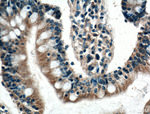
SCF Antibody in Immunohistochemistry (Paraffin) (IHC (P))

Search
Proteintech
SCF Polyclonal Antibody
{{$productOrderCtrl.translations['antibody.pdp.commerceCard.promotion.promotions']}}
{{$productOrderCtrl.translations['antibody.pdp.commerceCard.promotion.viewpromo']}}
{{$productOrderCtrl.translations['antibody.pdp.commerceCard.promotion.promocode']}}: {{promo.promoCode}} {{promo.promoTitle}} {{promo.promoDescription}}. {{$productOrderCtrl.translations['antibody.pdp.commerceCard.promotion.learnmore']}}
产品信息
26582-1-AP
种属反应
宿主/亚型
分类
类型
抗原
偶联物
形式
浓度
规格
纯化类型
保存液
内含物
保存条件
运输条件
产品详细信息
Immunogen sequence: ICRNRVTNN VKDVTKLVAN LPKDYMITLK YVPGMDVLPS HCWISEMVVQ LSDSLTDLLD KFSNISEGLS NYSIIDKLVN IVDDLVECVK ENSSKDLKKS FKSPEPRLFT PEEFFRIFNR SIDAFKDFVV ASETSDCVVS STLSPEKDSR VSVTKPFMLP PVAASSLRND SSSSNRKAKN PPGDSSLH (28-214 aa encoded by BC074725 )
靶标信息
Stem cell factor (SCF) is the ligand of the c-Kit oncogene and is expressed by various structural and inflammatory cells in the airways. Binding of SCF by the c-Kit receptor leads to homodimerization of the receptor and the activation of signalling pathways such as PI-3, PLC-gamma, Jak/STAT, and MAP kinase pathways. SCF expression leads to the induction of mast cell survival and the expression and release of histamine, pro-inflammatory cytokines and chemokines. The inhibition of the SCF/c-Kit pathway leads to a decrease in histamine levels, mast cell and eosinophil infiltration, IL-4 production and airway hyperresponsiveness, suggesting this pathway may be a useful therapeutic target in inflammatory diseases such as asthma. At least two isoforms of SCF are known to exist.
仅用于科研。不用于诊断过程。未经明确授权不得转售。
生物信息学
蛋白别名: C-kit ligand; cloud gray; DKFZp686F2250; familial progressive hyperpigmentation 2; grizzle-belly; growth factor; H-SCF; Hematopoietic growth factor KL; Kit ligand; kit-ligand; M-SCF; Mast cell growth factor; MGF; polypeptide growth factor; SCF; SCF220; SCF248; Steel factor; steel factor/kit ligand; Stem cell factor; stem cell factor KL-1; unnamed protein product
基因别名: blz; Clo; Con; contrasted; DCUA; DFNA69; FPH2; FPHH; Gb; Kitl; KITLG; KL-1; MGF; SCF; SF; SHEP7; Sl; SLF; WS2F
UniProt ID: (Human) P21583, (Mouse) P20826, (Rat) P21581
Entrez Gene ID: (Human) 4254, (Mouse) 17311, (Rat) 60427